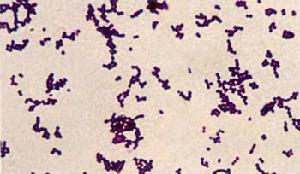
化膿性鏈球菌

簡介
化膿性鏈球菌
化膿性鏈球菌細胞沿一個平面分裂,常排列成鏈狀的細菌。革蘭氏染色陽性,但在陳舊培養基或膿液標本中常呈陰性。廣泛分布於自然界。分為致病性和非致病性兩大類。根據在血瓊脂培養基上的溶血特徵可分為三種不同類型:甲型(α) 溶血性鏈球菌又稱草綠色鏈球菌,菌落周圍出現草綠色溶血環,通常寄居在人的口咽腔、呼吸道及腸道中,致病力弱。乙型(β)溶血性鏈球菌產生強烈的溶血毒素,在血瓊脂培養基上,可使菌落周圍出現寬2~4毫米、界限分明、無色透明的溶血環,致病力強,能引起人類多種疾病、根據抗原構造不同,又分成A、B、C、D等18個群,在每一群中,因表面抗原的不同,又分成若干亞群,對人類有致病性的絕大多數屬於A群。丙型(γ)鏈球菌不溶血,對人類無致病作用。鏈球菌所致疾病具有複雜而多樣的特點,一方面,由於細菌類型多,且既有侵襲力也有毒素;另一方面,人體各組織器官均高度易感,且有變態反應機制參與發病。鏈球菌產生的侵襲性酶有:透明質酸酶、鏈球菌激酶和鏈道酶(streptodornase)等;產生的毒素有: 鏈球菌溶血素、紅斑毒素(一種耐熱的外毒素,又叫猩紅熱毒素,由A群鏈球菌中的部分菌株所產生)。變態反應性疾病如風 濕熱、急性腎小球性腎炎等,均可由A群鏈球菌感染引發。
抗原結構
主要有三種:
1.核蛋白抗原或稱P抗原,無特異性,各種鏈球菌均同,與葡萄球菌有交叉。
2.多糖抗原或稱C抗原系統族特異性抗原,是細菌壁的組成成份。對人致病的90%屬於A族,其次為B族,其它族少見。
3.蛋白質抗原或稱表面抗M、R、T、S等四種不同性制質的抗原組份,具有型特異性。是鏈球菌細胞壁的蛋白質抗原,位於C抗原外層,同族鏈球菌可根據表面抗原不同進行分型,如A族鏈狀菌可據此分為60多型。
按C抗原不同可分類A、B、C、D、E、F、G、H、K、L、M、N、O、P、Q、R、S、T等18個族。對人致病的大多屬於A族。A族又稱為化膿性 鏈球菌(streptococcusPyogenes)。
形態與染色
本菌為革蘭陽性菌,呈鏈狀排列,鏈的長短與 細菌的種類及環境有關,在液體培養基中易成長鏈。
培養特性
在血平板上可形成灰白色、圓形、凸起、細小 菌落,菌落周圍出現透明溶血環。
化膿性鏈球菌可以皮膚傷口或空氣飛沫傳播引起化膿性感染,如淋巴結炎、淋巴管炎.蜂窩織炎、癰、膿皰瘡等局部皮膚及皮下組織感染以及扁桃體炎、咽炎、中耳炎、 產褥熱等其他系統化膿性感染。
化膿性鏈球菌是致病力最強的一種鏈球菌,能產生多種毒素(鏈球菌溶素O和S、紅疹毒素)、M蛋白、 脂磷壁酸和鏈激酶、 鏈道酶、 明質酸酶等致病因子,可引起急性咽炎、呼吸道感染、 丹毒、膿皰病、軟組織感染、心內膜炎和 腦膜炎等,產毒株還可引起猩紅熱等。

